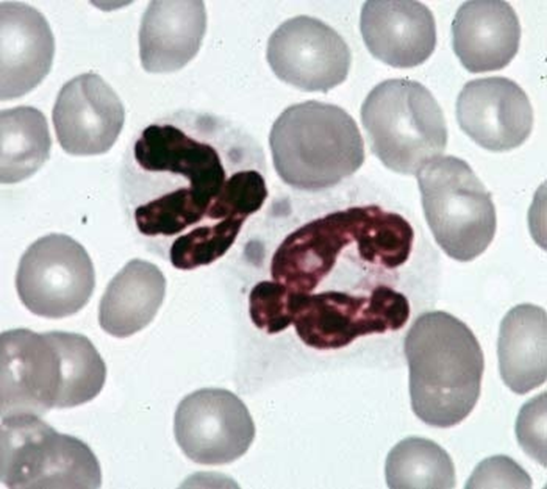

1/93
Looks like no tags are added yet.
Name | Mastery | Learn | Test | Matching | Spaced | Call with Kai |
|---|
No analytics yet
Send a link to your students to track their progress
What are cats good research models for?
Research models for neurology involved in locomotion and spinal trauma, retrovirus and zoonotic dz, developing tx for inherited dzs
Retrovirus research regarding cats
Models of Human AIDS and Potential Viral Vectors for Vaccine Delivery
FFV research in cats
generally asymptomatic and vehicle for gene therapy delivery
FeLV research in cats
Can cause fulminant dz and immunodeficiency/death or can be controlled and all but eliminated.
Studied to understand retroviral induced immunodeficiency, particularly hematopoietic tumors like acute lymphoblastic leukemia and lymphoma; following FeLV infection, some cats become persistently viremic and excrete virus through saliva and nasal secretions
What viruses in cats are models for HIV and AIDS?
FELV and FIV
Which helicobacter species can cats be naturally infected by?
H. pylori, and H. felis
Spinal Cord Injury (SCI) Research and Cats
• Preferred species for investigating SCI – small size, spinal cord is similar in length and anatomy to humans
• SCI model – create a lesion in spinal cord at last thoracic segment (T13)/ cats can regain normal locomotion showing that the spinal cord has intrinsic circuitry that generates locomotion
Cats and sleep research
• Popular sleep models – adult cats sleep up to 2/3rds of time, small size, gentle disposition
• Model of obstructive sleep apnea – cats are habituated to sleeping in hammock in various neck positions and to wear a CPAP (contiguous positive airway pressure)
Cats and parkinson’s
• Can be induced using 1-methyl-4-henul-1,2,3,6-tetrahydropyridine (MPTP); cats can recover unlike humans
• Cat MPTP model proposed as model of sleep disorders in Parkinson’s dz
Feline Genomics and Inherited Feline Dzs as Models of Human Dzs: CNS
Cats used to study CNS and cat brain has similar anatomy to human good model for gene therapy trials for neurological disorders like lysosomal storage dz
Chediak-Higashi syndrome
Blue Persian, recessive, partial oculocutaneous albinism
Ehlers-Danlos syndrome Type II
Himalayan and Domestic Short Hair
Globoid Cell leukodystrophy
Aka Krabbe’s dz
Hypertrophic cardiomyopathy
Main Coon cats
Klinefelter’s syndrome
XXY, Male Torti’s
MPS 1 (Mucopolysaccharidosis type 1)
-Is a Lysosomal storage disease cased by deficiency of alpha-L-iduronidase.
-The cat resembles the Hurler-Scheie syndrome in people.
-Clinically it is characterized by corneal clouding, facial dysmorphia, mental retardation (difficult to assess in animals), joint abnormalities, cardiovascular disease, and early death
Polycystic Kidney Dz
persian cats
Sphingomyelin lipidosis or Niemann-Pick Dz, type C
Siamese cats
Waardenburg’s syndrome
Autosomal dominant, irideal heterochromasia (2 different colored eyes), white fur, deaf

What condition is this and what breed of cat is it commonly seen in?
Waardenburg’s syndrome,

Neutrophils with large granules is commonly seen with which condition in cats?
Chediak-Higashi syndrome

What is the condition commonly seen in what breed of cat?
Endocardial fibroelastosis in burmese cats


What condition is this and what breed is predisposed?
Hypertrophic cardiomyopathy in main coon cats

What disease is seen here and what breeds are predisposed?
Ehlers danlos syndrome in himalayans and domestic short hairs
Similar pancreatic anatomy between cats and humans?
Pancreatic duct has common outlet into the duodenum with the bile duct at the major duodenal papilla
Accessory pancreatic duct retains duodenal outlet at the minor duodenal papilla

What condition is this and what age group of humans are affected?
Esophageal Achalasia
Random source cats (Class B)
o Valuable for training vet students and for establishment of genetic models of human dz
o 8-12wk isolation and observation period needed to ID dz, eliminate parasites, and vaccinate
o Non conditioned vs conditioned
Space requirements for cats
24” height, 3ft floor space <4kg, 4 ft floor space >4kg; queens with nursing need mor
Queens with nursing litters with other adults recommendations
Queens w/ nursing litters and kittens <4m shouldn’t be housed with other adults
Difference between AWA and guide for cat flooring requirements
AWA: Food/water pans NOT included in floor space. Litter pan included IF properly cleaned and sanitized. Resting surfaces count as floor space if so low that cat can’t occupy space below it
gUIDE: Food/water AND litter pans are NOT included in floor space
Same height and width requirements
Environmental factors for cats: temperature
64-84 F
Environmental factors for cats: noise
Continuous exposure >85 dB has auditory and non-auditory effects
Environmental factors for cats: light
325 lx (30 ft candles) 1 meter above floor is sufficient
Transport temperatures cats
not lower than 45ºF or higher than 85ºF for more than 4 consecutive hours when holding, or more than 45 minutes during transport
ventilation for cats: 2 walls opposing
at least 16% surface area of each wall and 14% total combined surface area of all walls
Ventilation for cats: 3 walls
8% of each opposing wall, 50% of the 3rd wall, 14% total surface area
Ventilation for cats: 4 walls
8% of each wall, 14% total surface area
Ventilation for cats: 1 wall
90%
Ventilation should be at least 1/3 of ventilation in upper half of enclosure?
yes
Transport number: older than 6 months
1 per enclosure by air
Transport number: 8 wks - 6 months
2 per enclosure by air, must be < 20 lbs.
Transport number: < 8 wks old
If less than 8wks: unweaned d/c with dam or weaned littermates together without dam (commercial air, private air, or ground all same)
Transport private air or ground for over 8 wk old cats
4 d/c over 8wks in same enclosure by ground or private air
How often should water be pffered?
Water offered once every 12 hours
Cats over 16 wks and food
d/c over 16wks age food offered every 24 hours
Cats under 16 wks and food
d/c under 16 weeks food offered every 12 hours
Cats food and water prior to transport
Food/water must be offered within 4 hours prior to transport
What does conditioning mean?
The process whereby a newly arrived random source animal is rendered free of parasites and diseases and is acclimated to the laboratory environment.
How long does the BB recommend for conditioning?
8-12 weeks
Feline coronavirus characteristics
ss RNA, enveloped, Nucleocapsid/spike glycoproteins
The two most common types of feline coronavirus?
FIP and FECV
Can FECV cross protect for FIP?
No, they are antigenically distinct
Feline enteric coronavirus characteristics
Subclinical or self-limiting diarrhea; most severe in recently weaned
Endemic in many colonies
What cells does FIP replicate in?
macrophages
Population most affected by FIP clinically
young and old
Can diagnostics differentiate between FIP and FECV?
No
Can you treat FIP once clinical signs start?
No

What virus of cats can cause this presentation
FIP, effusive or wet worm. The effusive or wet form – there is acute vasculitis with pleural and/or peritoneal effusions. The abdomen becomes progressively distended but is nonpainful on palpation. The volume of fluid is reflective of the chronicity of the infection.
Wet form is more common. Protein in fluid is very high (>35g/L); fluid cytology shows abundance of neutrophils and macrophages


What viral disease of cats can cause uveitis, hyphaema, and keratitis and systemic pyogranulomas
Non-efussive dry form of FIP.
The noneffusive form causes chronic pyogranulomatous disease. Its more insidious, but as it progresses, organ specific signs will manifest due to the pyogranulomas.
((Typically the liver, kidneys, and in more severe disease the pancreas, CNS and eyes will be effected. A necrotizing uveitis may be the only clinical sign. CNS lesions are usually located in the choroid plexus and meninges and they typically occur together with ocular lesions. ))
NO treatment once clinical signs are present. No diagnostic test available to differentiate FIP from FECV
Characteristics of feline panleukopenia virus
ssDNA, non-enveloped parvovirus. Persists in environment up to 1 yr, resists heat and many disinfectants
Shed in all body secretions
Fever, depression, anorexia, vomiting, diarrhea, cerebellar hypoplasia, leukopenia, fetal death, infertility, abortion, mummified fetuses
Tx: Supportive care, vaccination
Feline viral rhinotracheitis characteristics
DNA, enveloped, Alpha-herpes virus, Shed in ocular, nasal, pharyngeal secretions
Clinical signs of FHV
Conjunctivitis, keratitis, corneal ulcers, sneezing, fever, depression
80% of recovered cats become carriers
Diagnosis and treatment of FHV
Dx: Serology, PCR, virus isolation
Tx: Supportive care, antibiotics, antivirals (keratitis)
Vaccination (ML, IN) at 6, 9, 12 weeks
Feline calicivirus characteristics
Ss RNA, non-enveloped
Persists 8-10 days in environment
Transmitted by direct contact via nasal and ocular secretions
Calicivirus clinical signs
Fever, depression, sneezing, nasal discharge, oral and lingual ulcers, limping syndrome
Calicivirus diagnosis, treatment and prevention
Dx: PCR
Tx: Supportive care, antibiotics
Vaccination

What condition causes this pathology in cats?

Characteristics of Chlamydophila felis
Obligate intracellular parasite
Elementary bodies, intracytoplasmic inclusions
Chronic, relapsing, or latent infections
Shed in ocular discharge

What parasite is this?
Chlamydophila felis
Clinical signs, diagnosis, treatment and prevention of chlamydiosis in cats
Unilateral conjunctivitis, but can infect other eye within days
Dx: Conjunctival scrapings, culture, ELISA
Tx: Doxycycline
Vaccination may reduce severity and duration of signs
Mycoplasmosis in cats
Mycoplasma felis
Smallest free living microbe, lacks rigid cell wall
Considered commensal, but if recovered from lungs, considered pathogenic
Persistent conjunctivitis, sneezing, nasal discharge
Dx: Conjunctival scrapings, culture
Tx: Doxycycline
FeLV characteristics
ss RNA, enveloped, Type “C” virus
Replicates in BM, salivary glands, respiratory epithelium
Non-cytopathic, escapes cell by budding
Transmitted by saliva; lasts 48 hours in environment
What virus causes these syndromes in cats


FIV characteristics
ss RNA exogenous virus
Family Retroviridae, Subfamily Lentivirinae
Immunodeficiency
Replicates in CD4, CD8, possibly B cells
Incidence highest in outdoor free-roaming males
Transmission by bite wounds, in utero, nursing
What zoonotic organisms can be spread by cat bites?
Pasteurella multocida
Capnocytophaga canimorsus
Bartonella henselae

What disease is this in cats?

liver fluke of cats
Platynosomum concinnum: 2 intermediate hosts: Land snails and lizards. Chronic inflammation and fibrosis of bile ducts

cat breeds predisposed to amyloidosis?
abysinnian- renal amyloidosis, siamese- hepatic amyloidosis

What diseases is being shown here?
Muscular dystrophy. Reduced dystrophin expression in a cat colony U of Missouri-Columbia Reduced level of activity, stiff gait, and general skeletal muscle hypertrophy (involving tongue and diaphragm)
What are the components of spina bifida?
Neural tube anomaly causing megacolon, fecal and urinary incontinence, uterine inertia, agenesis of the sacrum and agenesis of the coccygeal vertebrae, absence of cauda equina.

What condition?

What are cats good models for in regards to surgery?
pediatric intubation in medical schools
Core vaccines for cats: FVRCP
Core vaccinations: FHV, FCV, FPV
< 16 weeks, one dose of modified live virus (MLV) FHV1, FCV, and FPV recommended every 3-4 weeks from 6-8 weeks of age, with final no sooner than 16 weeks of age
>16 weeks of age, two doses MLV FHV1, FCV, and FPV given 3-4 weeks apart
After a booster at one year, revaccination suggested every 3 years thereafter for cats at low risk of exposure.
According to recommendations of the vaccine-associated sarcoma task force, these vaccines are administered in the right forelimb below the elbow
Use of FPV MLV vaccines should be avoided in pregnant queens and kittens less than one month of age
Core Vaccine: rabies
Single dose of killed or recombinant vaccine at 12-16 weeks of age. Adult cats with unknown vaccination history should also receive a single dose of killed or recombinant vaccine
For recombinant vaccines, booster yearly
For the killed vaccines, booster is required at one year, and thereafter, rabies vaccination should be performed every 3 years using vaccine approved for 3-year dosing
According to recommendations of the vaccine-associated sarcoma task force, rabies vaccines are administered subcutaneously as distally as possible in the right rear limb.
Core vaccines: FELV

Protein requirements compared to dogs
require twice the amount compared to dogs
importance of taurine in diet
Decreased cysteinesulfinic acid decarboxylase
Bile acid conjugation
High levels in heart, retina, CNS, and skeletal muscle
Deficiency Þ retinal degeneration, reproductive failure, deformities, and mortality, and dilated cardiomyopathy
Most commercial diets have recommended levels but can administer taurine PO
Two most common dietary related diseases in cats
hepatic lipidosis
FLUTD
Hepatic lipidosis characteristics
Diet change or other stressor precipitates anorexic episode
Obese cats at higher risk
Severe hepatocellular lipid accumulation
Can be life-threatening
Gradually introduce new diet
FLUTD characteristics
Previously referred to as FUS
Most important factor = urine pH
Mg ammonium phosphate or struvite crystals form when urine pH > 6.5
Clinical signs include hematuria, dysuria, and pollakiuria
Management
Feed diets that acidify urine
Avoid diets high in Mg
Feed canned diets = high water content
Onset of puberty in cats
5-9 months of age
Body weight > 2 kg
Other factors
+10 more hours of light in a 24-h period required for reproduction cycle
Estrus cycle characteristics
seasonally polyestrus, photoperiod
Estrus cycle phases
5 Phases
Proestrus 1.5-3 days
Estrus 4-7 days
Interestrus 1-3 weeks
Diestrus 45-50 days
Anestrus Oct-Dec/Induced by short days (8hr light)
breeding behaviour in cats
Queen goes to tomcats – female are polygamous
Induced ovulators
HT releases GnRH ÞLH surge
Induced by:
Cervical and vagina stimulation
Human Chorionic gonadotropin
Pseudopregnancy or pregnancy